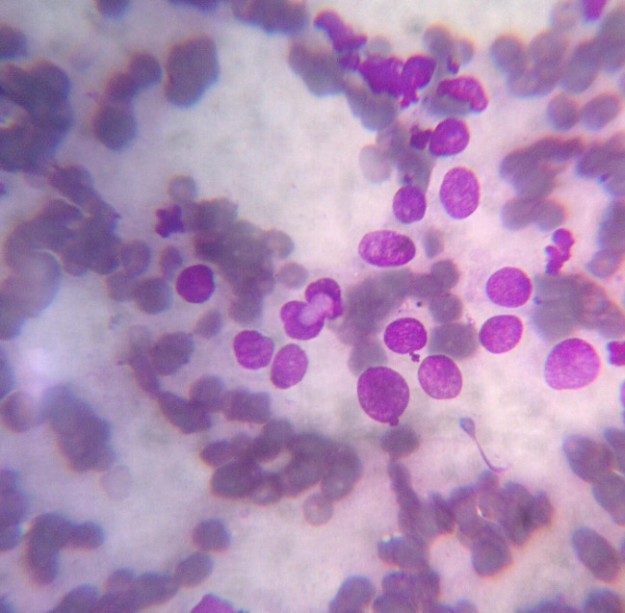

Revisión veterinaria básica
El veterinario no sólo está para emergencias, sino para resolver cualquier duda que le pueda surgir al propietario y si nos concienciamos de la necesidad de realizar revisiones periódicas a nuestras mascotas, éstas estarán más controladas y podremos actuar de forma preventiva.